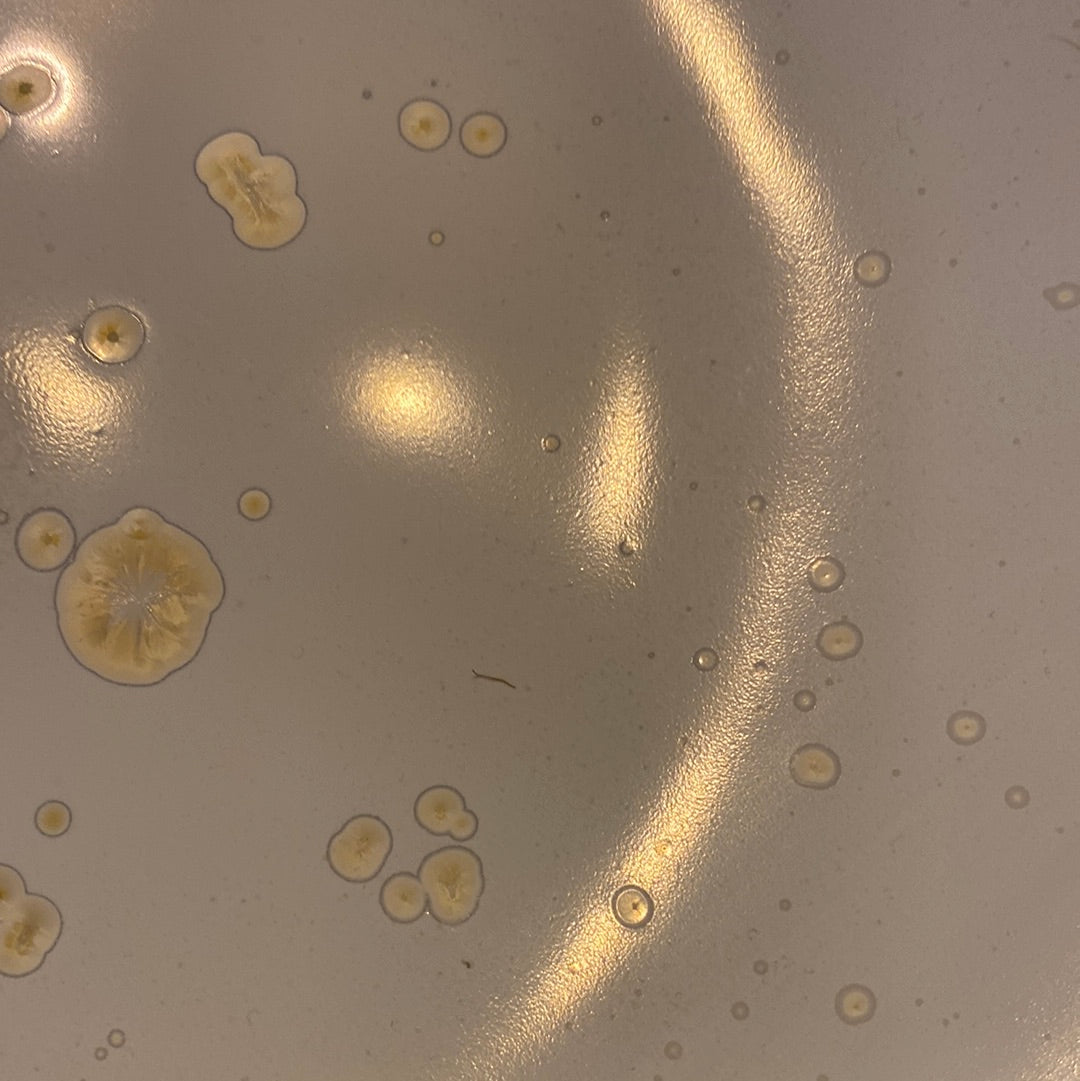

Svalehuset
Stor middags tallerken / fad
Stor middags tallerken / fad
Normalpris
275,00 DKK
Normalpris
Udsalgspris
275,00 DKK
Stykpris
pr.
Tilgængelighed for afhentning kunne ikke indlæses
Endelig fandt jeg dette stel!! :) har ledt længe efter et stel med guldmetal detaljer som kan komme i opvaskemaskinen og det kan dette - jubiii!! Så nemt at mixe med andet stel eller vælg tallerkner fra samme serie. Hvert produkt har sit eget udtryk.
Denne store tallerken eller serverings fad måler ca 29,5 cm i længden - 27 cm i bredden og 4 cm i højden.